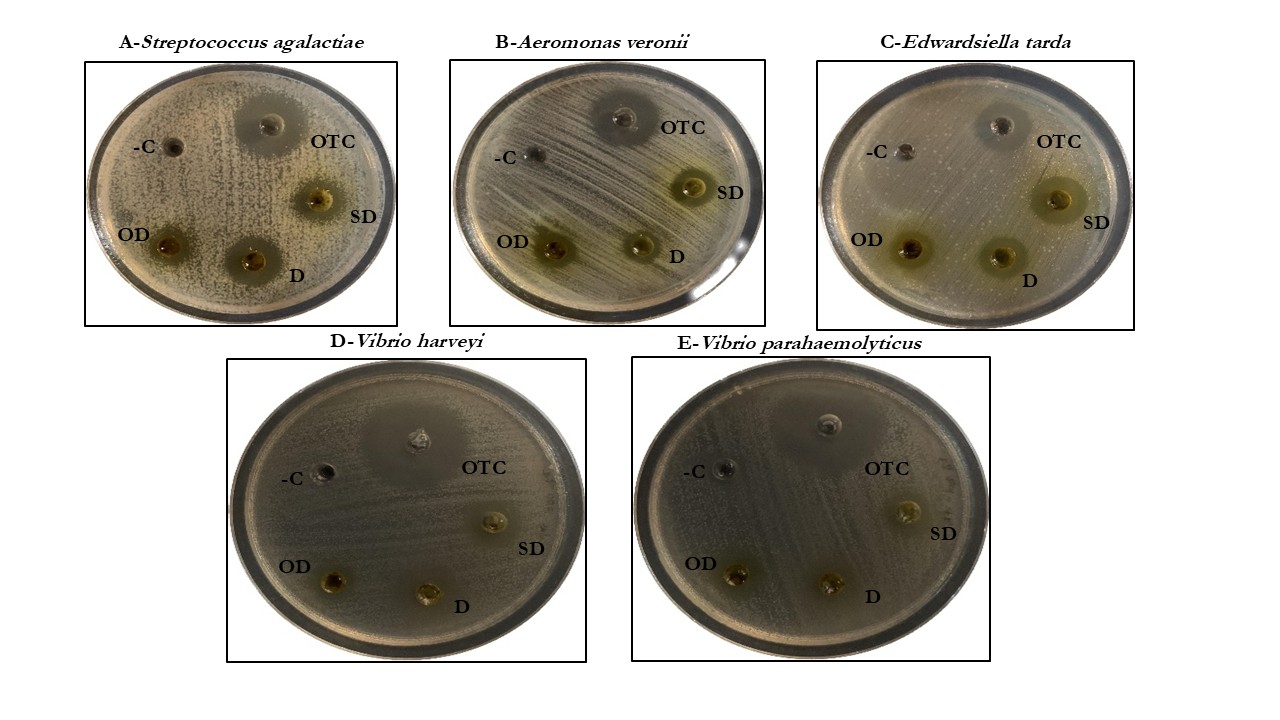
Antibacterial activity of calamansi, Citrofortunella macrocarpa, fruit waste extract against aquaculture pathogens

Vol. 31 No. 01 (2026): JAN-FEB

Vol. 31 No. 01 (2026): JAN-FEB
Published:
Research Articles
-
Oily Wastewater Remediation using Polyurethane Sponges Coated with an Optimised Amount of Graphene Nanoplatelets
Stella Mitchell School of Engineering, Faculty of Innovation and Technology, Taylor’s University, No.1, Jalan Taylor’s, 47500 Subang Jaya, Selangor, Malaysia…
-
Increasing compound hot-rainfall extreme in Thailand during 1970-2022
Wutthichai Paengkaew Climate Change and Environmental Research Center, Department of Climate Change and Environment, Thailand Atsamon Limsakul Climate Change and…
-
Antibacterial activity of calamansi, Citrofortunella macrocarpa, fruit waste extract against aquaculture pathogens
Michael James Salutan College of Fisheries and Marine Sciences, Mindanao State University at Naawan, 9023 Naawan, Misamis Oriental, Philippines Christopher…
-
Morphophysiological response of iceberg lettuce (Lactuca sativa L.) to rice hull biochar
Cyril John C. Nagal University of the Philippines – Los Baños, Laguna, Philippines DOI: https://doi.org/10.14456/apst.2026.4 Keywords: Iceberg lettuce Morphophysiological response Rice…
-
Effects of different doses of sports liniment with massage on changes of myoglobin among male Muay Thai fighters: A randomised cross-over pilot study
Lee David Johnson School of Physical Therapy, Faculty of Associated Medical Sciences, Khon Kaen University, Khon Kaen, Thailand https://orcid.org/0009-0004-5627-4606 Kwanchayanawish…
-
Hydrogel-forming microneedles with epigallocatechin gallate and 4-(hydroxymethyl)-phenylboronic acid for antibacterial wound healing and drug release
Naritsara Suwatsrisakun Department of Chemical Engineering, Faculty of Engineering, Khon Kaen University, Khon Kaen 40002, Thailand Duangkanok Tanangteerapong Department of…
-
Anti-inflammatory and antioxidant effect of tomato extract (Solanum lycopersicum L.) in lipopolysaccharide-induced mice macrophage cells
Oeij Anindita Adhika Faculty of Medicine, Maranatha Christian University, Bandung 40164, West Java, Indonesia Fen Tih Faculty of Medicine, Maranatha…
-
Use of water hyacinth-based compost to improve the growth and biochemical properties of lettuce (Lactuca sativa var. crispa L.)
Jutarut Iewkittayakorn Division of Biological Science, Faculty of Science, Prince of Songkla University, Hat Yai, Songkhla 90110, Thailand Aunkamol Kumngen…
-
Potential effects of astaxanthin on the growth performance, survival, and colour brightness of Channa marulioides (Bleeker, 1851) in feed domestication
Rizal Akbar Hutagalung Aquaculture Study Program, Department of Marine Science and Fisheries, Aquaculture Study Program, Pontianak State Polytechnic, Pontianak, 78124,…
-
Application of silicon improved rice productivity and reduced chalky rice
Engku Hasmah Engku Abdullah Paddy and Rice Research Center, Malaysian Agricultural Research and Development Institute, 43400 Serdang, Selangor, Malaysia Azizah…
-
KIT/PDGFRA mutations and their associations with clinicopathological parameters in gastrointestinal stromal tumors of Vietnamese patients
Linh Dieu Vuong Pathology and Molecular Biology Center, National Cancer Hospital K, 30 Cau Buou Street, Thanh Tri, Hanoi, Vietnam…
-
Microclonal success of avocado using different scions and clonal rootstock varieties
Francisco O. Esgrina, Jr. College of Agriculture, Agribusiness, Forestry, and Food Sciences, Cotabato Foundation College of Science and Technology, Doroluman,…
-
Optimization of γ-aminobutyric acid production by Lactiplantibacillus plantarum isolated from Vietnamese fermented pork (nem chua) using central composite design
Nguyen N Thanh Department of Microbial Biotechnology, Institute of Food and Biotechnology, Can Tho University, Can Tho City 90000, Viet…
-
Green extraction and characterization of Durian (Durio zibethinus Murray cv. ‘Puyat’) rind pectin
Jan Irv Bitoon Department of Food Science and Chemistry, College of Science and Mathematics, University of the Philippines Mindanao, Mintal…
-
Phosphate adsorption from home industry laundry wastewater in Indonesia using teak wood-based activated carbon
Gendy Ayodya Alfarizi Department of Environmental Engineering, Faculty of Engineering, University of Jember, Kalimantan Street 37, 68121 Jember, East Java,…
Review Articles
-
Exploring bioengineering strategies to enhance microbial-driven rock weathering for climate mitigation
Noppadol Panchan Department of Process and Industrial Engineering, School of Engineering and Industrial Technology, Mahanakorn University of Technology, Bangkok 10530,…
-
Indian blackberry: Unveiling its health and organoleptic delights and use in beverage fermentation
Arpita Ghosal Department of Biotechnology, Brainware University, Kolkata 700125, India Puja Agnihotri Department of Biotechnology, Brainware University, Kolkata 700125, India…